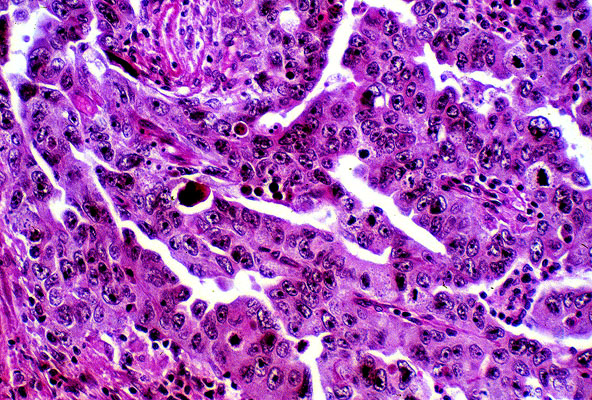

Embryonal carcinoma, histology
Click picture to enlarge. Close window to return
The tumor is composed of cells that vary in size and shape. The nuclei of these cells seem to overlap and the cell borders are not distinct. There are prominent mitotic figures and some cells appear to have condensed nuclei indicative of apoptosis.